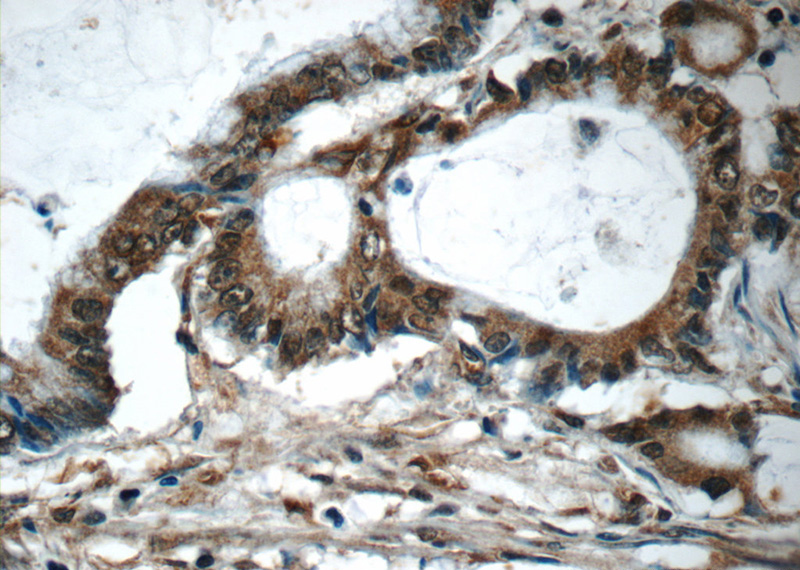
Immunohistochemistry of paraffin-embedded human colon cancer tissue slide using Catalog No:115417(SMAD3 Antibody) at dilution of 1:50 (under 40x lens)

-
Product Name
SMAD3 antibody
- Documents
-
Description
SMAD3 Rabbit Polyclonal antibody. Positive WB detected in Jurkat cells, A431 cells, A549 cells, HeLa cells, SH-SY5Y cells. Positive IF detected in HeLa cells. Positive IHC detected in human colon cancer tissue, human liver cancer tissue. Observed molecular weight by Western-blot: 48 kDa
-
Tested applications
ELISA, WB, IHC, IF
-
Species reactivity
Human; other species not tested.
-
Alternative names
DKFZp586N0721 antibody; DKFZp686J10186 antibody; hMAD 3 antibody; hSMAD3 antibody; HSPC193 antibody; HsT17436 antibody; JV15 2 antibody; MAD homolog 3 antibody; Mad3 antibody; MADH3 antibody; Mothers against DPP homolog 3 antibody; SMAD 3 antibody; SMAD family member 3 antibody; SMAD3 antibody
-
Isotype
Rabbit IgG
-
Preparation
This antibody was obtained by immunization of Peptide (Accession Number: NM_005902). Purification method: Antigen affinity purified.
-
Clonality
Polyclonal
-
Formulation
PBS with 0.1% sodium azide and 50% glycerol pH 7.3.
-
Storage instructions
Store at -20℃. DO NOT ALIQUOT
-
Applications
Recommended Dilution:
WB: 1:200-1:2000
IHC: 1:20-1:200
IF: 1:10-1:100
-
Validations

Jurkat cells were subjected to SDS PAGE followed by western blot with Catalog No:115417(SMAD3 Antibody) at dilution of 1:600
Immunohistochemistry of paraffin-embedded human colon cancer tissue slide using Catalog No:115417(SMAD3 Antibody) at dilution of 1:50 (under 40x lens)

Immunofluorescent analysis of HeLa cells using Catalog No:115417(SMAD3 Antibody) at dilution of 1:25 and Rhodamine-Goat anti-Rabbit IgG
-
Background
SMAD3, also named as hMAD 3 or Mad3, is a 425 amino acid protein, which contains one MH1 domain and one MH2 domain. SMAD3 localizes in the nucleus and cytoplasm. SMAD3 plays an essential role in development and maintenance of self-tolerance and is a critical mediator of the TGFB signaling pathway. SMAD3 is involved in TGFB dependent regulation of steroidogenesis and in T-cell response to TGFB.
-
References
- Ma B, Kang Q, Qin L, Cui L, Pei C. TGF-β2 induces transdifferentiation and fibrosis in human lens epithelial cells via regulating gremlin and CTGF. Biochemical and biophysical research communications. 447(4):689-95. 2014.
- Dong Z, Lu X, Yang Y. IL-27 alleviates the bleomycin-induced pulmonary fibrosis by regulating the Th17 cell differentiation. BMC pulmonary medicine. 15:13. 2015.
- Zhang X, Xiao J, Li R. Metformin alleviates vascular calcification induced by vitamin D3 plus nicotine in rats via the AMPK pathway. Vascular pharmacology. 2016.
Related Products / Services
Please note: All products are "FOR RESEARCH USE ONLY AND ARE NOT INTENDED FOR DIAGNOSTIC OR THERAPEUTIC USE"
